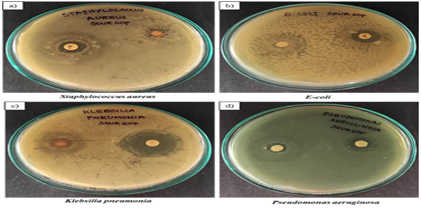

Current Issue (In Progress)
Volume -12, Issue - 1, September 2025

https://doi.org/10.29294/IJASE.12.1.2025.4871-4884
Cervical spondylosis is a degenerative condition of the cervical spine that affects over 85% of individuals above 60 and nearly 25% under 40. Although X-rays are the most accessible imaging modality, manual interpretation achieves only 68.3% accuracy, often requiring costly CT or MRI scans for confirmation. To address this limitation, we developed CervNet, a multimodal deep learning model that... Read More

https://doi.org/10.29294/IJASE.12.1.2025.4885-4903
Hybrid cloud environments often face challenges in balancing workloads, managing resources, and ensuring resilience, which can lead to performance bottlenecks and higher costs. To address this, the Hyper Responsive Artificial Intelligent based Hybrid Cloud Load Balancer (HRAIHCLB) is proposed as an AI-driven system that integrates three key modules: the AI Driven Load Prediction Distributor... Read More

https://doi.org/10.29294/IJASE.12.1.2025.4904-4921
Wireless Sensor Networks (WSNs) are widely used in mission-critical domains such as environmental monitoring, industrial automation, and defense. However, they face two major challenges: vulnerability to malicious node attacks and high energy consumption, both of which degrade network performance and shorten operational lifespan. This study aims to develop a unified framework that simultaneously... Read More

https://doi.org/10.29294/IJASE.12.1.2025.4922-4929
We propose a novel technique for high-density, all-optical magnetic recording based on vector diffraction theory. Our results demonstrate that a doughnut-shaped Gaussian beam with circular polarization (CPDGB), when tightly focused through a high numerical aperture (NA) lens, can generate nanoscale magnetization domains via the Inverse Faraday Effect. For NA = 0.85, the focused beam produces a... Read More
https://doi.org/10.29294/IJASE.12.1.2025.4930-4943
Annona muricata leaves and fruits are known to possess notable pharmacological properties; however, a comprehensive analysis of their secondary metabolites remains limited. This study aimed to quantify the secondary metabolites present in various solvent extracts of A. muricata leaves and fruits. Among the solvents tested, ethanol extracts exhibited the highest concentrations of phenolic acids... Read More

https://doi.org/10.29294/IJASE.12.1.2025.4944-4957
Sargassum wightii, marine seaweed from the family Sargassaceae, is renowned for its diverse biological activities, including antibacterial, antitoxic, antidiabetic, and anti-inflammatory properties. These effects are attributed to the phytoconstituents present in the seaweed. In this study, we aimed to evaluate the pharmacognostic, phytochemical, and physicochemical profiles of S. wightii.... Read More

https://doi.org/10.29294/IJASE.12.1.2025.4958-4976
Water availability underpins both socioeconomic development and ecosystem sustainability. This study investigated the surface hydrological characteristics of the Bennihalla Basin, spanning Dharwad and Gadag districts in a hard rock terrain dominated by Archaean meta sedimentary rocks (Meta Greywackes and Granitoids). Thirty-seven soil samples were analyzed for moisture content, organic matter,... Read More

https://doi.org/10.29294/IJASE.12.1.2025.4977-4983
To evaluate machine learning algorithms' mental workload estimation using NASA-TLX subjective evaluations in undergraduate students during multitasking. The study includes 74 students taking the Labin the Wild multitasking tests and NASA-TLX self-assessment. Participants rated six workload factors. KNN, Naive Bayes, and Extra Trees were tested using stratified k-fold cross-validation.... Read More

https://doi.org/10.29294/IJASE.14.1.2025.4984-5006
This review systematically evaluates the multiscale behavior, mechanical performance, and durability of various fibre-reinforced concrete (FRC) systems tailored for tunnel lining applications. Traditional tunnel linings often suffer from limited post-cracking ductility and inadequate crack control under complex loading, leading to durability concerns and increased maintenance costs. By... Read More

https://doi.org/10.29294/IJASE.12.1.2025.5007-5016
This study investigates passive flow control mechanisms to delay flow separation and enhance aerodynamic performance on wing surfaces. The NACA 2412 airfoil is selected for its high lift characteristics at low angles of attack. A flow velocity of 12 m/s is maintained, aligning with the rated wind speed of the subsonic wind tunnel and relevant non-dimensional parameters. The wing surface... Read More

https://doi.org/10.29294/IJASE.12.1.2025.5017-5025
: This study focuses on addressing the issue of moisture ingress in polymer composites, a factor that often compromises structural performance and limits service life, especially in humid or outdoor conditions. A hybrid composite was fabricated using pineapple fibre as reinforcement and waste plastic particles as filler, aiming to improve resistance to water absorption. Composites with varying... Read More

https://doi.org/10.29294/IJASE.12.1.2025.5026-5034
In this research, the properties of the 2-Amino-5-Bromo Benzaldehyde (2A5BB) molecule are studied using the Gaussian 16W software package, employing the B3LYP method with the 6-311++G(d,p) basis set. Mulliken charge analysis shows that the most significant value of charge for C5 is due to the polar bond of the COH aldehyde, and the atoms constituting the nitrogen bond possess the smallest... Read More

https://doi.org/10.29294/IJASE.12.1.2025.5035-5050
Landslides represent a recurrent hazard in mountainous regions, notably in the geologically fragile Nainital district of Uttarakhand, India. This study develops a data-driven landslide susceptibility model using k-Nearest Neighbors (KNN) and Naive Bayes (NB) classifiers, integrating 273 inventoried landslide scars and eight geo-environmental conditioning factors. The dataset was partitioned into... Read More

https://doi.org/10.29294/IJASE.12.1.2025.5051-5066
Nowadays, renewable energy sources are a good alternative to conventional energy sources like coal and fossil fuels, which pollute the environment, as they provide clean, sustainable, and eco-friendly power while reducing greenhouse gas emissions. Finding sustainable solutions for the rapidly increasing global energy consumption has become one of the major challenges of the modern world, which... Read More

https://doi.org/10.29294/IJASE.12.1.2025.5067-5082
The extracellular polymeric compounds found in bacterial biofilms make them highly resistant to traditional antibiotics, posing a serious threat to industrial systems, medical equipment, and human health. The inability of conventional therapies to break through biofilms frequently results in chronic infections, higher mortality rates, and financial losses. By utilizing the unique properties... Read More

https://doi.org/10.29294/IJASE.12.1.2025.5083-5100
Frequent Pattern Mining (FPM) from streaming data poses significant challenges due to the need for real-time processing, limited memory availability, and handling the evolving nature of data. Existing algorithms often fall short in adapting to successive transactional updates, leading to reduced accuracy, inefficient memory usage, and poor scalability. To address these challenges, this study... Read More

https://doi.org/10.29294/IJASE.12.1.2025.5101-5116
: A stable agricultural economy, food security, and quality of life largely depend on efficient plant Pest Detection (PD). Rapid insect and pest infestations severely affect annual crop yields, and existing detection methods often face security and performance limitations. Globally, researchers are exploring scientific approaches that leverage Cloud Computing (CC) systems for pest detection. To... Read More

https://doi.org/10.29294/IJASE.12.1.2025.5117-5126
: Parking has become a significant issue in urban areas, especially as the majority of people in metro regions increasingly rely on private vehicles. With the growing popularity of Smart Parking (SP) systems based on the Internet of Things (IoT) and recent technological advancements, addressing parking challenges has become crucial. This research focuses on alleviating traffic congestion caused... Read More

https://doi.org/10.29294/IJASE.12.1.2025.5127-5137
Anaemia and gestational diabetes mellitus (GDM) are prevalent comorbid conditions during pregnancy that significantly affect maternal health and fetal development. This study investigates the interrelationship between anaemia and GDM, their individual and synergistic influence on behavioural alterations, and the consequent implications for quality of life (QoL) among pregnant women. Conducted at... Read More

https://doi.org/10.29294/IJASE.12.1.2025.5138-5150
Understanding soil infiltration characteristics is vital for effective water resource management, especially in semi-arid regions with complex geological settings. This study investigates the infiltration dynamics of different soil types in the semi-arid hard rock terrain of the Bennihalla Basin, with a focus on identifying potential sites for artificial groundwater recharge. In contrast, red... Read More

https://doi.org/10.29294/IJASE.12.1.2025.5151-5161
This study presents a green, rapid, and eco-friendly method for synthesizing silver nanoparticles (AgNPs) using Moringa oleifera leaf extract as a natural reducing and stabilizing agent. A visible color change from whitish-yellow to dark brown indicated nanoparticle formation, which was further, validated by surface plasmon resonance (SPR) peaks that lies at 460 nm in the UV–vis spectral... Read More